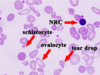
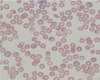

protein sorting/post translational mod. & hematopoiesis Flashcards
(50 cards)
Secretory vesicles contain which molecules destined for secretion outside the cell?
Gastric acid Digestive enzymes Lung surfactants’ Sebum

Extracellular vesicles can carry protein and nucleic acids. what are they used for?
cell signaling. They are also linked to metastatic cancers.
How does a protein get into the mito?
Tom/Tim23 complex!
Once its in, the signal sequence is cleaved and protein is mature.

Protein kinases include…………….
They recognize consensus sequences, can phosphorylate multiple substrates, and can phosphorylate single or multiple amino acids.
tyrosine kinases or serine/threonine kinases
Chronic myelogenous leukaemiais a slow-growing cancer of the blood-forming tissue (bone marrow) leading to the production of too many white blood cells. It is caused by a rearrangement (translocation) of genetic material and fuses a part of the ABL1 gene from chromosome 9 with part of the BCR gene on chromosome 22, creating an abnormal fusion gene called BCR-ABL1.
The product of ABL1 gene is what?
a protooncogene tyrosine protein kinase.
What are the two types of ubiquitination?
– Monoubiquitination: involved in DNA repair, regulation of transcriptionand internalization of transmembrane proteins.
– Polyubiquitination: involved in proteosomal degradation of modified protein, endocytic trafficking and inflammation.
Ubiquitination requires what three types of enzymes?
ubiquitin-activating (E1), ubiquitin-conjugating (Ubc), and ubiquitin ligase (E3).
What are the 2 ubiquitination diseases we talk about?
- Renal cell carcinoma (involving Von-Hippel-Lindau gene which encodes E3 ubiquitin ligase)
- Breast cancer (involves BRCA1, which is human tumor suppressor gene. It has E3 ubiquitin ligase activity. Mutation that affects the ubiquitin ligase function are found in various cancers.)
Is acetylation spontaneous or is it catalyzed by acetyltransferases?
Can be either!
One example of acetylation is acetylation of………….. by asprin.
Cox1/Cox2
The most common protein acetylation occurs at what residues?
lys
………… of tumor suppressor p53 is necessary for its activation.
Acetylation
The addition of a methyl group usually occurs on the nitrogen side-chain of what aa’s?
lysine or arginine
Histone methylation is catalyzed by histone methyltransferase. what serves as a donor of methyl group?
S-adenosylmethionine (SAM)
Histone methylation can be associated with transcriptional repression or activation. For example, Trimethylation of histone H3 at……….. is an active mark for transcription. Dimethylation of histone H3 at………….. is a signal for transcriptional silencing.
Lys 4
Lys 9
Hydroxylation most frequently occurs at…………… residue.
proline
What modification is important in stabilizing collagen? What enzyme is used?
Hydroxylation with prolyl 4-hydroxylase
–This reaction requires iron and α-ketoglutarateto carry out the oxidation.
……………. deficiency can lead to less stable collagen, which can manifest itself as the disease scurvy.
Vitamin C
* Vitamin C is necessary to return the iron to its oxidized state.
Carboxylation is a posttranslational modification of glutamate (Glu) residues, to γ-carboxyglutamate, in proteins. Carboxylation occurs in the liver and is performed by γ-glutamyl carboxylase. What vitamin is required as a cofactor?
Vitamin K
Carboxylation occurs primarily in proteins involved in the blood clotting cascade. Mutations in the gene for…………………… are associated with multiple coagulation factor deficiency.
γ-glutamyl carboxylase
γ-carboxyglutamate binds…………, which is essential for its function.
Ca++
GPI-anchored proteins are co-translationally inserted into the ER membrane. The hydrophobic C-terminus is cleaved off and replaced with a GPI-anchor by GPI-transamidase. The GPI-protein is translocated to Golgi and then to the plasma membrane. GPI-anchored proteins can be what?
* Antigens (human carcinoembryonic antigen (CEA) is used as a cancer marker.
* Enzymes (alkaline phosphatases and acetylcholinesterase)

The GPI-anchored proteins on the surface of RBCs protect them from destruction by the complement system.
Somatic mutations in the X-chromosomal gene PIGA, which is an essential component of GPI-transamidase, is the most common cause of…………………………
paroxysmal nocturnal hemoglobinuria (PNH).
What can use glycosylation to shield from immune recognition?
Viruses